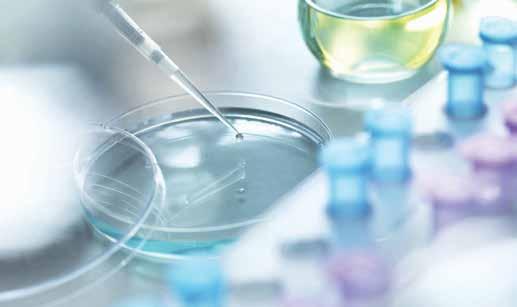

Nuestras Hitorias de Éxito


![]()






Año 9, edición 63
Alejandro Coronado Director
Lupita Hernández Comercialización
Carlos Márquez De Anda Studio Fotos
Odeth Vázquez Diseño editorial
Elsa Camarero Corrección de pruebas finas
Delia Salazar Eventos especiales
Impresa en Culiacán, Sinaloa
Las opiniones expresadas por nuestros colaboradores son a título personal y no necesariamente representan la filosofía de nuestra publicación revistaunicobc@gmail.com coronadoeditorialbc@gmail.com

(686) 157 55 81 Tel: (686) 554-32-82 www.unicobc.com.mx
únicoBC es una revista de edición mensual con reserva de derechos al uso exclusivo emitido por el Instituto Nacional de Derechos de Autor (Indautor) con número: 04-2014-102913093200-102
Registro: 2082584 del Instituto Mexicano de la Propiedad Industrial (IMPI)
Cuida el medio ambiente, recicla esta revista www.yoreciclomxl.org


Nuevo récord de visitas genera la edición #62.

Una graduación muy especial del Colegio de Ángela Nevárez.
La ensenadense Claudia Conte Buenrostro nos comparte todos sus logros alcanzados dentro del cine, teatro y televisión en exclusiva desde la ciudad de Nueva York, donde actualmente radica. No te puedes perder todos los detalles de esta interesante entrevista:
Pág. 16

Entregan plazas de servicio social profesional en la 16 de Septiembre.

La historia del golfista cachanilla Esteban Toledo.




En Plaza La Gran Vía de Mexicali se encuentra el consultorio de la doctora Claudia Machuca, considerado uno de los mejores en el noroeste del país en tratamientos de medicina estética facial.
Checa el especial a continuación:

Las personas que buscan tener una piel más saludable acuden al consultorio ubicado en Plaza La Gran Vía en Mexicali
“Soy la doctora Claudia Machuca, médico estético con más de 10 años de experiencia. Nuestra misión es resaltar la belleza de tu rostro porque tu salud y bienestar son lo más importante para nosotros.
Contamos con tecnología de vanguardia y tratamientos inyectables de marcas premium, aplicados por personal capacitado para cuidar y proyectar la mejor versión de ti.
Hoy en día, no es vanidad cuidarse, sino una parte esencial de tu bienestar personal. Queremos que nuestros con-
sultorios sean tu lugar de refugio, tu zona segura, donde podamos ayudarte a cuidar tu piel, potenciar tu belleza y recuperar tu seguridad. Es imposible detener el tiempo, pero podemos ayudarte a retrasarlo, y de eso me encargo yo. Nuestro equipo de profesionales ha crecido y ahora ofrecemos servicios no solo estéticos, sino también funcionales, como ftalmología y otorrinolaringología.
Además, contamos con cosmetólogas certificadas que reciben capacitaciones cons-
tantes para mejorar nuestros servicios.
Yo, la Dra. Claudia Machuca, estoy a cargo del área de inyectables y valoraciones, para determinar el mejor tratamiento para ti.
Agradecemos a nuestros pacientes por su preferencia, porque gracias a ustedes estamos en el top de médicos estéticos en el noroeste del país.
Te invito a que, si aún no has tenido la oportunidad de visitarnos, te tomes un tiempo y vivas la experiencia de belleza, arte y medicina estética con la Dra. Claudia Machuca”. PortadaBC







Dra. Claudia Machuca
Belleza, Arte y Medicina Estética
Ubicación: Plaza La Gran Vía, Local #4
Teléfono: 686 116 1268
Correo: dra.claudiamachuca@gmail.com

Para festejar con orgullo la identidad culinaria de Baja California, se celebró el centenario de la Ensalada Caesar’s en Tijuana, donde se dieron cita chefs internacionales, nacionales y locales para celebrar la trascendencia de este platillo.
El titular de la Secretaría de Turismo, Miguel Aguíñiga Rodríguez, informó que en el marco del Centenario de la Ensalada Caesar’s se realizaron varias actividades, entre ellas la gran cena de gala, en la que se develó una estatua en honor a César Cardini, quien fue dueño del restaurante donde Livio Santini incluyó por primera vez la Ensalada en 1924.
Se presentó el libro y vino conmemorativo creado por Casa Magoni, donde se ve plasmada la historia tras la creación de la Ensalada
Caesar’s, así como otras recreaciones de la ensalada por chefs de otras partes del mundo.
Se realizó la cena Gala Centenario y el Festival Centenario de la Ensalada Caesar’s. En todas las actividades se contó con la participación de talentosos chefs reconocidos, entre ellos Javier Plascencia y Nadya Fernández como anfitriones, destacó Aguíñiga Rodríguez.
Finalmente, el titular estatal de Turismo mencionó que este esfuerzo se realizó en conjunto con Promotora de Cultura de Baja California, FIDEM, FIDURT BC y el Consejo de Desarrollo de Tijuana. Las ganancias recaudadas serán destinadas para apoyar a la Fundación Tijuana sin Hambre.
Nota.- Con información del Departamento de Comunicación Social del Gobierno de Baja California




Por su trayectoria, espíritu de servicio y entrega a la comunidad, la estimada mexicalense María Cristina Terán de Félix fue distinguida con la medalla al mérito Concepción Sierra de Lanz Duret, máxima presea que damas voluntarias de la Cruz Roja Mexicana otorga a nivel nacional.
En una emotiva ceremonia celebrada en conocido centro gastronómico local y con la representación de la presidenta nacional de Damas Voluntarias de Cruz Roja Mexicana, Beatriz Nieves de Freaner, la coordinadora estatal de dicha agrupación, Tatiana Ivette Michelle Ramírez, hizo entrega del prestigiado reconocimiento.
María Cristina Terán Moreno de Félix, Cristina de Félix,
como mejor se le identifica, tiene entre sus innumerables méritos ser fundadora del Comité de Damas de Cruz Roja Mexicana, delegación Mexicali, B.C., institución a la que ingresó el 20 de febrero de 1997.
Tras agradecer el emotivo homenaje, Cristina de Félix señaló que pertenecer a la coordinación de Damas Voluntarias de Cruz Roja Mexicana fue una experiencia llena de aprendizajes, retos y momentos inolvidables.
“A lo largo de mi trayectoria en diversas organizaciones sociales, he tenido la fortuna de conocer a personas maravillosas y comprometidas y he aprendido que juntos podemos lograr grandes cosas y marcar la diferencia en la vida de quienes más lo necesitan”, dijo.

Agradeció la presencia y paciencia de su familia que, dijo, ha sido pilar fundamental y fuente de inspiración en su servicio a la comunidad e hizo extensivo el reconocimiento recibido a todos aquellos que han compartido esta hermosa travesía, a cada persona que ha confiado, colaborado y que ha sido parte de este camino.

En exclusiva para únicoBC, la artista originaria de Ensenada y radicada en Nueva York, nos cuenta los logros alcanzados en su carrera dentro del cine, teatro y televisión
Por Alejandro Coronado
Claudia Conte Buenrostro es una chica originaria de Ensenada, Baja California, quien desde hace algunos años destaca en el medio artístico y su sede es la ciudad de Nueva York.
Antes de emigrar a la “urbe de hierro”, Conte Buenrostro realizó estudios dentro de la Facultad de Artes de la Universidad Autónoma de Baja California en Mexicali, de donde se graduó en el 2017.
En Nueva York ha tenido la oportunidad de prepararse en academias de prestigio como Stella Adler Studio of Acting, Professional Conservatory 2023 y Summer Conservatory en el 2021, así como Bachelor in Audio-Visual Media. Y en nuestro país en la CasAzul Escuela de Artes Escénicas y Audiovisuales de la Ciudad de México.
Esta preparación ha sido fundamental para ser considerada en proyectos importantes como la serie Monarca en Netflix y la película Un Papá Pirata de Amazon Studio. Además ha grabado comerciales para firmas reconocidas como Coca-Cola y McCafé de McDonalds en los Estados Unidos.
Parte de los retos más importantes en su carrera son en el teatro, donde ha interpreta-
do diversos papeles arriba del escenario.
Destacan las obras The Memory of Water (VI), Knock Knock (woman), Moscow, Moscow (Olga), Last Summer at Blue Fisch Cove (Lil) y Don Quijote (Antonia Quijano).
Todos estos logros en la carrera de Claudia han requerido de un gran esfuerzo y desarrollar su talento bajo la supervisión de importantes directores. Además de trabajar a lado de figuras consagradas.
Fue precisamente a la edad de 21 años, trabajando como asistente en la película Gringo, se dio cuenta que podría interpretar personajes.
“En una plática con Diego Cataño le pregunté cómo le había hecho para ser actor y me dijo que estudiando. Fue así que me di cuenta que quería ser actriz y me puse a estudiar”.
“Recuerdo que en la Navidad del 2018 le dije a mis papás las intenciones de dedicarme a la actuación, a lo que mi mamá respondió: Te estabas tardando. Claro, ellos vieron desde siempre que me gustaba todo lo relativo a la actuación”.
Así que con el apoyo de los progenitores y superando la difícil etapa de la pandemia en el 2020, Claudia Conte Buenrostro se dedicó a reforzar sus estudios en Nueva York, Así han llegado las propues-


tas de trabajo como una serie vía streaming que próximamente se anunciará en los Estados Unidos por una importante empresa de grabación. Para más detalles pueden checar su página de Instagram en: @claudiaac





Una cantidad superior a las 100 mil impresiones de publicaciones como lo cataloga Facebook, generó la portada #62 de únicoBC, Nuestras Historias de Éxito. Esto viene a reafirmar nuestro liderazgo como el medio de comunicación no tradicional con mayor número de seguidores en la región.
A 9 años de su lanzamiento, nuestra plataforma 360° luce cada vez más completa con más de 50 mil seguidores en Facebook, el enorme éxito de
nuestro programa únicoBC.TV y las novedades que cada semana se ofrecen en los espacios de YouTube e Instagram.
A esto se une la presencia de nuestra marca en Tijuana, Ensenada y Rosarito. La grandeza de únicoBC se sigue extendiendo con nuevos espacios exclusivos que sólo un medio con nuestra calidad editorial puede ofrecer.
Sigue nuestro portal oficial para estar enterado del material especial que sólo puedes encontrar en: www.unicobc.com.mx


La publicación especializada con más seguidores en Baja Califormia
www.unicobc.com.mx

Laboratorios Estrada confirma su liderazgo en la capital de Baja California con 11 sucursales debidamente equipadas y con personal altamente calificado para una atención de primer nivel. Destacan su matriz ubicada en avenida Francisco Madero 1711 en la colonia Nueva y avenida República de Uruguay 876, fraccionamiento Sonora. También puede encontrarlos en Plaza España, Pedregal, Carbajal, Américas, calzada Cetys, Anáhuac, Palaco, Pueblo Nuevo Michoacán y Monarcas. La atención es de lunes a sábado, además de ofrecer el servicio a domicilio llamando al 686-554 6008.
Para cualquier duda pueden
consultar su página web estradalaboratorios.com o llamar al 01800 626 5223.
Laboratorio Estrada está certificado por su control de calidad Prevecal.





Por Damaris Martínez
El pasado 27 de junio, los egresados de la Licenciatura en Enfermería recibieron sus plazas de Servicio Social Profesional.
El evento marca un paso crucial en la formación de los egresados como licenciados en Enfermería, brindándoles la oportunidad de aplicar sus conocimientos en contextos reales de atención de salud.
En total, se otorgaron 72 plazas, de las cuales 59 fueron asignadas por entidades federales y estatales (SSA, Issste, IPEBC e Issstecali), y 13
fueron del Programa Universitario.
Durante este acto, se contó con la presencia de los jefes de enseñanza y responsables de área de diversas instituciones, quienes apoyaron y orientaron a los egresados en el inicio de esta etapa profesional.
En Grupo Educativo 16 de Septiembre se reafirma el compromiso de formar profesionales capacitados y comprometidos con la salud pública y el bienestar de la comunidad.
Felicitamos a todos los egresados y les deseamos éxito en esta importante etapa de su carrera.




La generación 2023-2024, con especialidad en colorimetría del Colegio Privado de Estilistas y Coloristas de Ángela Nevárez, concluye sus estudios
En medio de un gran ambiente se realizó la graduación de la generación 2023-2024 con especialidad en colorimetría del Colegio Privado de Estilistas y Coloristas de Ángela Nevárez en Mexicali.
La cita fue un reconocido centro social de la localidad el pasado 6 de julio de 2024, a donde acudieron las alumnas
acompañadas de sus familiares y amigos.
Las nuevas estilistas que cumplieron su periodo escolar de manera exitosa fueron María del Carmen García Gaytán, Melviz Flores Ramos, María de los Ángeles Cervantes Ochoa, Lourdes Gómez, Silvia Según Tovar y Brenda Alicia Buzo Camarena.
Las seis alumnas recibieron diplomas y constancias de es-
tudios con reconocimiento por parte de la Secretaría de Educación Pública.
En esta ocasión los padrinos de generación fueron el reconocido estilista Juliano Santander, así como los empresarios Lupita Hernández y Alejandro Coronado, quienes estuvieron acompañados por Marcos López del Colegio de Estilistas.







Un total de 17 alumnos de sexto grado de primaria resultaron ganadores de la Olimpiada del Conocimiento Infantil (OCI) 2024
Mexicali fue la sede para celebrar la premiación de 17 estudiantes distinguidos de sexto grado de primarias de Baja California, que resultaron ganadores de la Olimpiada del Conocimiento Infantil (OCI) 2024, certamen desarrollado por la Secretaría de Educación federal y estatal, en el que se evalúa y premia la excelencia académica.
Las y los estudiantes distinguidos pertenecen a los siguientes municipios: 9 de Tijuana, 5 de Mexicali, 1 de Rosarito, 1 de Ensenada y 1 de San Quintín.
Los alumnos reconocidos de Tijuana son Luis Fernando Aguilar Camacho de la escuela Primaria Rancho Santa Fe; Javier Mendoza Barrera del Instituto Libertad; Juan Diego López Perdomo de la 5 de Diciembre; Kevin Alexander López Carrera de Escudo Nacional; Justin Joaquín Méndez Sánchez de Felipe Pescador; Isaac Nuño Rodríguez de Juan Ma. De Salvatierra; Ámbar Raquel Garibay Rosales de Gregorio Torres Quintero; Fátima Alexia de la Torre Vargas de California y Brianna Aldapa González de Libertador de América.
De las primarias de Mexicali Discovery American Academy, República Mexicana, Amado Gil Castro, Gabriela Mistral y Prof. Salvador Jiménez Gómez. Se premió a David Alejandro Encinas Bermúdez, Leonardo Barreto Vargas, José Ignacio Jacobo Aldrete, Nicole Valentina Rivas Palomera y René Bastidas Polanco, respectivamente. De la escuela primaria Sentimiento Purépecha de Playas de Rosarito se reconoció a David Ernesto García Ríos: de la Benito Juárez de Ensenada a Alexander Domínguez Pinzón y de la


Frida Kahlo de San Quintín a Mariano Lara Sigala. Finalmente, el director estatal de educación primaria, Marcos Ernesto Macías Briones, recordó que el concurso se organiza desde 1961 y se ha realizado con los nombres “Ruta de la Independencia” y “Concurso Nacional para el Reconocimiento a la Excelencia en el Sexto
Grado de Educación Primaria”. A a partir de 1993, al incorporarse al sistema nacional de estímulos para estudiantes de educación básica y media superior, se denominó como OCI, premiando la excelencia académica de niñas y niños.
Nota.- Con información del Departamento de Comunicación de la Secretaria de Educación en Baja California



El mexicalense es considerado uno de los mejores golfistas en la historia de nuestro país
Por Alejandro Coronado
Esteban Leobardo Toledo
se hizo golfista profesional en 1986 y para 1994 logró su ingreso a la gira PGA, la más importante del mundo y donde pocos mexicanos han logrado firmar tarjeta.
Toledo se mantuvo dentro de la gira PGA de 1998 a 2004, donde logró jugar los más importantes torneos del mundo a lado de las máximas leyendas del golf.
Su mejor año fue el 2000, cuando ocupó la segunda posición en el BC Open realizado en Nueva York y ganar el Abierto Mexicano, donde logró quebrar el dominio que los extranjeros ejercieron por más de 24 años en ese torneo.
Ha representado a nuestro país en un total de seis Campeonatos Mundiales de Golf como los de 1992, 1994, 1995, 1998, 2002 y 2006.
En el 2005 logró la victoria en el Lake Erie Charity Classic celebrado en Findley Lake, Nueva York, dentro de la Nationwide Tour.
De cuna humilde, Toledo es

originario del barrio de la Pozolera, donde para poder sobrevivir fue boxeador hasta los 19 años antes de lanzarse de lleno al mundo del golf al solicitar trabajo de caddy dentro del Club Campestre, donde
aprendió los secretos de este selecto deporte.
“Perico” Toledo, como le dicen sus amigos desde la infancia, nació un 10 de septiembre de 1962 en Mexicali, Baja California.

En la tercera edad, las mujeres enfrentan desafíos específicos relacionados con su salud ginecológica, siendo algunas de las condiciones más comunes la atrofia vaginal, el prolapso genital, la incontinencia urinaria y en casos menos frecuentes, el cáncer y las infecciones vaginales.
Por lo anterior, el Hospital Materno Infantil de Mexicali hace un llamado a este sector poblacional a no descuidar su salud.
José Rojas Serrato, director del nosocomio, explicó que estas condiciones son en gran medida el resultado de los cambios hormonales asociados con la menopausia.
La disminución en los niveles de estrógeno puede llevar a la atrofia vaginal, causando
sequedad, irritación y dolor.
Además, el debilitamiento de los músculos pélvicos contribuye al prolapso genital y a la incontinencia urinaria.
De tal forma que es fundamental que las mujeres de la tercera edad estén atentas a los signos y síntomas de estos problemas ginecológicos.
La detección temprana permite un tratamiento más efectivo y mejora la calidad de vida, por lo que se recomiendan visitas regulares al médico para exámenes de rutina y discutir cualquier preocupación relacionada con la salud vaginal y pélvica.
Según la Organización Mundial de la Salud (OMS), las condiciones ginecológicas mencionadas afectan a un porcentaje significativo de
mujeres mayores de 60 años en todo el mundo. A medida que la población adulta, especialmente las mujeres, alcanza la tercera edad, se anticipa un aumento en la incidencia de enfermedades ginecológicas relacionadas con esta etapa de la vida. Es crucial que las personas en este grupo de edad prioricen el autocuidado y la atención temprana para mantener la salud ginecológica. Esto incluye la vigilancia regular, la detección precoz de síntomas y el acceso oportuno a cuidados médicos especializados, garantizando así una mejor calidad de vida y bienestar en la vejez.
Nota.- Con información del Departamento de Comunicación de la Secretaría de Salud en Baja California


















En Plaza La Gran Vía de Mexicali se encuentra Ixchel, Arte e Identidad Mexicana.
Este santuario para todos aquellos que buscan sumergirse en la riqueza cultural de nuestro país, tiene sus puertas abiertas de lunes a domingo. En este lugar puedes encontrar desde textiles para dama y caballero, así como cerámicas, accesorios, artesanías y recuerdos, todos elaborados por manos de destacados artesanos mexicanos.
Además, para que la experiencia sea más agradable existe un área con un rico café que puedes acompañar de productos muy especiales de nuestra región.
Sin duda toda una experiencia, donde cada vez son más las personas que acuden a Ixhel en busca de ese detalle muy nuestro que hace la diferencia en cualquier evento.
Para más detalles consulta sus diferentes redes sociales en Facebook o Instagram.


ArmAndo Sánchez díAz

LEE HASTA EL FINAL SI DESEAS PONERTE EN FORMA
Sí hay diferencias muy marcadas entre un entrenamiento para un joven menor de 30 y para personas que pasan los 50.
Basado sólo en mi experiencia sobre lo que me ha funcionado y mantenido en forma durante más de 45 años a mis 61 años de edad.
Entre los 20 y 29 años cuando más fuerte estaba, “entrenaba” religiosamente de una y media a dos horas intenso un promedio de 22 días por mes.
Después de los 40 años mi entrenamiento ya no era entrenamiento; se convirtió en “ejercicio” sin el objetivo de competencia y no pasaba de 60 min, 16 a 18 días por mes. Y después de los 50 mi tiempo de ejercicio no pasa de 45 minutos 12 a 15 días por mes.
De los 20 a los 35 años de edad ejecutaba con barra olímpica 8 a 11 series pesadas de sentadillas, remos o pres de banca, dependiendo de la rutina, más otros ejercicios. Y la mitad de esas series eran de alta intensidad. Era entrenamiento con objetivo de competencia.
Después de los 40 años no ejecutaba más de 5 ó 6 series de los ejercicios anteriores y las dos últimas series eran algo pesadas, pero no tanto como antes y no siempre. Después de los 50 hago mucho menos.
Antes de los 30 años mi capacidad de recuperación era muy alta. Hoy, aunque me mantengo en forma mi capacidad de recuperación ha bajado mucho y tardo más días en reponerme después de un día de ejercicio
fuerte (para mi edad) por lo tanto requiero más descanso.
Hoy juego tenis una a dos veces por semana y si entrenara en el gimnasio como cuando tenía 20 años, no tendría energía para jugar tenis.
Esto que expongo a veces no es bien comprendido por la persona que no tiene experiencia en el ejercicio; me refiero al novato en el ejercicio pero que ya pasa los 40 años de edad, incluyendo el entrenador novato que no sabe lo que se siente tener 50 años o más y puede caer en el error de sobre ejercitar al alumno viejo.
¡¡Ojo...!!
Si deseas tener resultados con el ejercicio, necesitas aprender a exigir a tu cuerpo lo suficiente pero no de más.
Armando Sánchez Díaz Medina En forma con Armando Busca mis videos en Facebook, YouTube, Instagram. Av. Mariano Arista 1568. Mexicali. 686 5670092 enfrmaconarmando@gmail.com



deliA SAlAzAr

Con la llegada de las vacaciones de verano, Mexicali se ve desolado y ¡cómo no! Si la mayoría de las familias deciden “huir” del calor y disfrutar del clima frío en Rosarito y Ensenada. Pero no me dejará mentir, porque los que se quedan en Mexicali, taaambién disfrutan del descanso del tráfico y del ruido, aunque a decir verdad, en estos tiempos cada vez son más los carros que andan en el calorón. Nosotros nos quedamos, pero no quiere decir que no nos enteramos dónde andan nuestros lectores, les agradecemos que nos compartan su divertido verano.
Descanse en paz Yolanda Escamilla de Tafoya, quien ya reposa en Dios. Enviamos el pésame a su familia los García Tafoya, a todas las amistades y que su legado de amor les dé fortaleza en tan difíciles momentos.

Felicidades y lo mejor a los integrantes de la nueva mesa directiva 2024-2025 integrada por Cristóbal Hernández como presidente, Raymundo Jiménez León como tesorero y Ernesto Zúñiga, Saúl Elizondo Solís, en medio ambiente; Valentín Aarón Jerez Valdez, en diabetes y cáncer infantil; Jesús Corrales Romero, en niñez y juventudes; Ramsés Arturo Razo Zapata, en ayuda humanitaria y mitigación del hambre y Mauricio Martin Higuera en comunicación y mercadotecnia. Durante la ceremonia se entregaron reconocimientos a diversos miembros del Club de Leones por su compromiso con la organización, además de designar al León Presidente, Cristóbal Hernández con el máximo galardón del Club como “León del Año”. Muchas felicidades Cristóbal.

Primero por su reciente cumpleaños que festejó en casa con sus papás Fernando y Paola, su hermano Diego y demás familia y amigos cercanos. Y segundo, un deseo de éxito con tu música, Disasster, el grupo al que pertenece y es el vocalista, se viene presentando en diferentes escenarios. A mediados de julio abrieron los escenarios de los Domingos Culturales con una buena dosis de metal.
Felicitamos cariñosamente a la mamá de nuestra querida Issadora Lara, Lourdes Guerra, quien no pudo estar más contenta con su festejo. Su familia se la llevó de viaje y todos fueron con ella. Empezaron en París, lugar a donde la cumpleañera soñaba ir para compartir con sus nietos la historia de sus antepasados, el viaje espectacular y sin duda, Lourdes lo recordará por siempre. Que siga el festejo!
Bravo!! Una joven deportista y promesa en el deporte, hija de Tuti Solórzano y Roberto Pérez, ella es Sonia Pérez Solórzano, quien tuvo una excelente participación en los Nacionales Escolares llevados a cabo en Puebla en categoría Primarias en vallas y salto de altura, disciplinas donde se llevó medallas en ambas pruebas. Gran orgullo para nuestra amiga Tuti, ¡Felicidades!


Fiesta de Colores en LA Cetto el 10 de agosto, es uno de los eventos más populares y esperados, tan así que ya están agotados los boletos. El evento iniciará a las 12:30 horas con la misa de acción de gracias y bendición de la primera cosecha, encabezada por el obispo de Ensenada, Rafael Valdez Torres. Este año se conmemora el 95 aniversario de la Casa Cetto, fundada por Angelo Cetto. En la Fiesta de Colores 2024 también habrá menú de cuatro tiempos, el cual es creación del chef David Salgado, además del ‘after party’.
Verano igual a Fiesta de la Vendimia, son varios los eventos en el Valle de Guadalupe en el marco del ya tradicional festejo de cosecha de uva.
Moenia regresa a Mexicali a un concierto el 17 de agosto en Tennessee House of Music. Porque las mexicalenses merecen un novio que las trate bonito, La Clase llega a Mexicali con dos únicas funciones con Leonardo de Lozanne y José Eduardo Derbez, quien dice que en el amor no hay reglas, pero en el ligue sí y será quienes traten el tema en el Ceart en el Salón A el 22 de agosto en punto de las 19:00 horas. Los boletos en 840 y 955 pesos.
EL XXXIV Concurso de paellas “Dr. Ramón García Ocejo” en Viña de Liceaga el 18 de agosto promete ser un evento culinario exquisito y además visitado por residentes de todo el Estado y de la República. Son 84 vinícolas las que ofrecerán degustación de más de 160 etiquetas de vinos, 80 equipos concursan para realizar la mejor paella de la tarde y ofrecen muestras de sus preparaciones, además de contar con un programa musical para amenizar esta experiencia.
Aunque faltan varios meses, nos llega la invitación para el 11 de octubre para la exposición

Van Gogh The Immersive Experience México. Y como no estar emocionados si Mexicali fue tomado en cuenta para conocer una exposición inspirada en el genio holandés Vicente Van Gogh. Todos los que asistan podrán conocer su vida, sentir y su arte y ser parte de recorrido fantástico de sus creaciones. Será en el Ceart del 11 de octubre al 15 de enero del 2025. Así que oportunidad sí la hay. Se podrá hacer un recorrido virtual por los lugares que lo inspiraron en sus creaciones, efectos visuales, sonido y mucho más. Así que hay que agendarlo.
Delia R Salazar Montaño 27 años de experiencia en el círculo social de Mexicali deliarsalazar@gmail.com

Estudiantes del TEC de Monterrey tienen eventos durante sus campañas financieras con el objeto de reunir fondos para ayudar a jóvenes con sus estudios profesionales
Con el objetivo de recaudar fondos para el fondo de becas para estudiantes Bajacalifornianos que deciden estudiar en el TEC de Monterrey, se realizó el segundo Torneo de Golf con causa.
El evento deportivo se or-
ganizó por la directiva de la Asociación de Estudiantes Bajalifornianos en Monterrey (Aebmac) presidida por Juan Carlos Bejarano como actividad previa a las ya tradicionales convenciones de verano de los jóvenes que pasan sus vacaciones en el Estado.
El arranque del partido fue desde temprana hora, los participantes se registraron minutos antes de las 9 para disfrutar de la mañana deportiva con causa que finalizó a las 3 de la tarde con una comida y premiación de los ganadores.


Además de colaborar con la causa, los jugadores se divirtieron y la pasaron de lo mejor.

Jugadores y apasionados del golf se reunieron en Baja Mar para participar del torneo pro becas de la Aebmac.
Inauguran la Exposición “Aureola” en el Casino de Mexicali con el apoyo del maestro Carlos Coronado
Grupo de Pintura “Polvo de Estrellas” del Maestro Carlos Coronado, inauguró la Exposición “Aureola” en el Casino de Mexicali en compañía de invitados y el gerente general del Club, Óscar Erenas.
Se llevó a cabo en las instalaciones del club social y deportivo donde socios se dieron cita a la ceremonia mientras las damas, mostraron sus diferentes trabajos plasmados.
Fueron varias las pinturas,
el arte que las alumnas del maestro Coronado exhibieron en el espacio dentro del Casino para ser admirado por sus familiares, quienes orgullosos las acompañaron.
Se ofreció un ambigú y bebidas para los asistentes.










